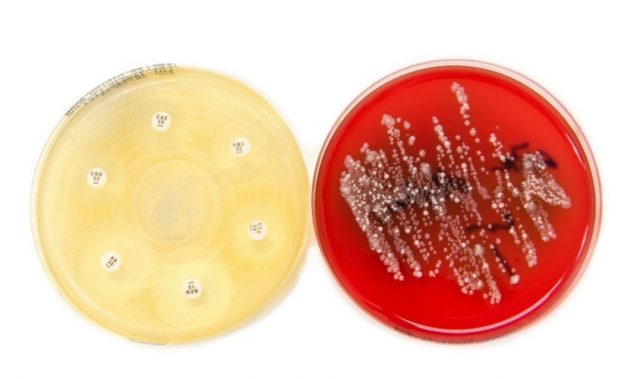
Shedding Light On Bacterial Infections

AsianScientist (Jul. 16, 2012) – A team of scientists in Singapore has discovered how bacteria respond to salts in their environment and how these salts can alter the behavior of specialized salt sensor bacterial proteins.
The discovery sheds light on how microbes detect levels of salts or sugars in their watery environments – a problem in biology that has been studied for more than 30 years.
Led by Assistant Professor Ganesh Anand and Professor Linda J. Kenney from the National University of Singapore, the researchers found that microbes detect salt levels by specialized molecules or proteins on the bacterial surface that change shape in response to the external salt concentration.
One of the important environmental stresses for bacteria is the changing concentration of salts. For instance, some can live in fresh water (a low salt environment) or in the guts of humans (high salt environment).
The findings, which were published recently in the EMBO Journal, showed that bacteria have elaborate mechanisms for sensing and responding to changes in the environment.
Using a powerful combination of a tool called amide hydrogen/deuterium exchange mass spectrometry (HDXMS) accompanied by molecular biology and biochemistry, the scientists probed the mechanism by which changes in salt concentrations are sensed by a receptor protein.
They found that salt detecting proteins are like molecular springs, or “slinky toys.” The proteins are constantly shifting from a condensed spring form to an extended form. Increasing the salt concentration dampens this spring-like movement, which activates the protein. In other words, the less spring-like the protein, the higher is its activity.
This protein movement may provide a unified model of how bacteria sense their environment, and may be also relevant to cells from all organisms which detect and respond to changes in environmental salts and sugars.
The research team is now working on studying the protein in its native membrane by embedding the bacterial sensor protein in an artificial membrane. Through these studies, they hope to understand how the membrane contributes to overall protein activity, structure, stability, and response to salts.
The article can be found at: Wang LC et al. (2012) The inner membrane histidine kinase EnvZ senses osmolality via helix-coil transitions in the cytoplasm.
——
Source: NUS.
Disclaimer: This article does not necessarily reflect the views of AsianScientist or its staff.